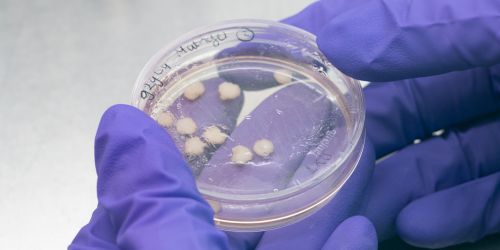

Samen met wetenschappers en donateurs werken we aan een proefdiervrije toekomst. Er bestaan inmiddels verschillende alternatieven voor dierproeven. Welke alternatieven dit zijn en wat ze inhouden, lees je hier!
Dierproeven worden al honderden jaren verricht. In 1981 werd het aantal dierproeven voor het eerst geregistreerd: meer dan anderhalf miljoen. Dankzij technologische ontwikkelingen en wetenschappelijke kennis, is het aantal dierproeven met ruim de helft verlaagd naar 477.960 in 2021.
Een mooie daling, maar elk proefdier is er één te veel. Ondanks dat muizen, honden, katten en varkens helemaal niet op mensen lijken, worden er nog steeds talloze onderzoeken op hen verricht.
We zien dat het anders kan: steeds vaker ontdekken we nieuwe manieren om onderzoek te doen zónder dieren. Dat bespaart niet alleen veel dierenleed, maar zorgt ook voor betere en betrouwbaardere resultaten voor mensen. Klik hieronder op de proefdiervrije onderzoeksmethoden en lees hoe zij bijdragen aan een proefdiervrije wereld!
Proefdiervrije alternatieven
Diervrij onderzoek
Proefdiervrij betekent niet altijd 100% diervrij. Net zoals vegetarisch eten niet hetzelfde is als diervrij eten (veganistisch). Om cellen in wetenschappelijk onderzoek levend te houden en te laten groeien, wordt er het fetal calf serum (FCS) gebruikt.
Wij financieren geen projecten waarin gebruik wordt gemaakt van kalfsserum.